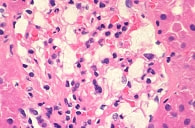

全身性エリテマトーデス(SLE)の診断
さまざまな臓器に病変か起こる全身性エリテマトーデス(SLE)。どこかおかされるかは人それぞれ、症状のあらわれ方も多様です。かつては「診断の難しい」病気でしたが、それを容易にしたのが「分類基準」です。
診断には「分類基準」が用いられる

SLEの診断はひとつの症状や検査所見の異常だけで行うものではありません。診断にはアメリカリウマチ学会が作成した分類基準が用いられます。この基準は11項目からなり、このうちの4項項目以上にあてはまれば、SLEである可能性が高くなります。ただし、この分類基準はもともと疫学調査などの目的につくられたものですので、機械的に項目をあてはめて診断するのは、正しい方法とはいえません。SLEの診断は、あくまでも専門医が総合的な観点から行うものです。
SLEの分類基準(米国リウマチ協会による)
顔面紅斑点 | 頬隆起部を中心とした慢性紅斑。隆起なし、またはあり。鼻唇溝に出ない傾向がある。(頬に出る慢性的な紅斑。鼻の下の溝部分には出ない傾向がある) |
---|---|
円板状紅斑 | 隆起した紅斑、角化鱗屑、毛嚢塞栓を伴う。萎縮しうる。(隆起した丸い紅斑。一部がうろこ状になったり、紅斑の中心が治ったあとのように白くなることもある) |
光線過敏症 | 日光暴露による異常反応としての皮疹 (日焼けのことではありません)。 |
口腔内潰瘍 | 口腔、鼻咽喉。無痛であることが多い。 (口の中や鼻、のどに潰瘍ができる) |
関節炎 | 2領域以上の末梢関節の 圧痛、腫脹、非破壊性。 |
蔣膜炎 | a.胸膜炎、b.心外膜炎 (胸や心臓に水がたまる) |
腎障害 | a.尿蛋白>0.5g/dayまたは>3+、b.円柱細胞(0.5g/日以上の持続的タンバク尿か、円柱細胞=尿中の成分が円柱状に固まったもの) |
神経障害 | a.けいれん、または b.精神症状(a、bともほかの誘因がないもの) (けいれん発作、あるいは精神症状) |
血液異常 | a.溶血性貧血、b.白血球<4000/μℓ、2度以上、C.リンパ球<1500/μℓ、2度以上、d.血小板<10万/(薬剤によらない)、のいずれか (溶血性貧血または4000/mm³以下の白血球減少または1500/mm³以下のリンパ球減小または10万/mm³以下の血小板減少) |
免疫異常 | a.抗二本鎖DNA抗体、b.抗Sm抗体、c.抗リン脂質抗体陽性:抗力 ルジオリピンlgGまたはlgM、ループスアンチコアグラント、梅毒反応偽陽性(6カ月以上) (免疫学的異常 抗DNA抗体や抗Sm抗体、抗リン脂質抗体などがみられる) |
抗核抗体 | 蛍光抗体法による。どの時点で陽性でもよい。薬剤誘発性ルーブスによるものは除外する。 |
上記のうち4項目以上にあてはまるとSLEと分類する(出現時期は一致しなくてよい)
※「分類」とは医学用語ですが、「診断」とほぼ同義です。
SLEの診断のための検査

抗DNA抗体のなかでも2本鎖DNAに対する抗体が出現するのがSLEの特徴です。DNAはもともと二重らせん構造をしており、2本の鎖からできています。通常は、この2本鎖DNAに対する抗体はできませんが、SLEでは活動期に一致して高値を示します。このほか、SLEの診断をつけるためや、臓器病変の有無をみるためにさまざまな検査が行われます。血液検査では赤血球、白血球、血小板の数を調べます。SLEではいずれの成分も減少する可能性があるからです。
尿検査では、尿中のタンパクの量を調べるとともに、細胞成分(=尿沈直)を調べます。尿検査は腎炎の有無をみるために必要な検査です。また、胸部X線写真、心電図などは必ず行われる検査です。必要に応じて、超音波検査、胸部CT検査、脳ではCT検査に加えてMRI検査、脳血流シンチグラフィ(SPECT)などが行われます。
SLEの活動性をみる検査
一方、血液の中の補体は免疫反応で消費されるために減少します。補体の検査法は、血清補体価(CH50)とC3、C4測定がありますが、いずれも活動期に一致して低下します。抗力ルジオリピン抗体は抗リン脂質抗体症候群で出現します。血液の中の免疫複合体も活動期に一致して増加します。
腎生検とは、超音波検査で腎臓の位置を確認しながら、からだの表面から腎臓に針を刺して組織を取り、採取した組織を顕微鏡で検査する方法です。この組織をみることによって、腎炎の程度や活動性の程度を知ることができます。この情報をもとにして、ステロイド薬の投与量を決めたり、あるいはステロイド治療の有効性を予知することができます。ただし、むくみがあったり、出血しやすい患者さんには腎生検は行いません。またこの検査は、患者さんに検査の必要性を説明し、文書で同意取得ができた場合にかぎって行います。
